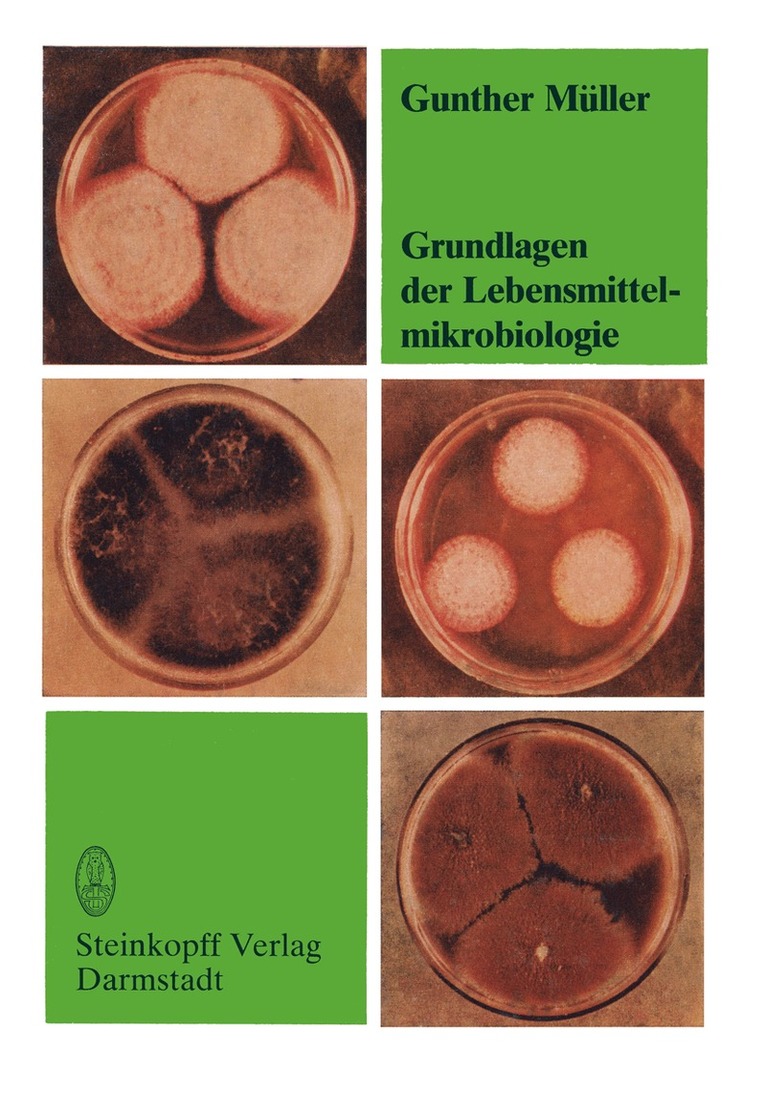

G. Muller – författare
Visar alla böcker från författaren G. Muller. Handla med fri frakt och snabb leverans.
11 produkter
11 produkter
Häftad, Engelska, 2018
656 kr
Skickas inom 5-8 vardagar
Transformative Property Law honours Professor AJ Van der Walt (1956-2016) - scholar, mentor, and teacher. As the first incumbent of the DST/NRF South African Research Chair in Property Law his primary research goal was to develop the theoretical foundations for the transformation of property law in post-apartheid South Africa. Covering topics that are at the forefront of global thinking on property law, Transformative Property Law consists of 20 essays by a combination of senior and young scholars from South Africa, the United States of America, the United Kingdom, Ireland, the Netherlands, Belgium, and Zimbabwe. The essays focus on the themes that Professor Van der Walt developed during the first 10 years of the research chair, namely: (a) the single system of law and subsidiarity principles; (b) the marginality principle; (c) the development of the common law of property; (d) constitutional property law; and (e) property theory. This volume also includes a list of all Professor Van der Walt's research outputs and a list of all the Masters and Doctoral students that he supervised during his career.
Häftad, Franska, 2018
153 kr
Skickas inom 5-8 vardagar
Häftad, Tyska, 2022
1 039 kr
Skickas inom 5-8 vardagar
Inbunden, Tyska, 2022
1 331 kr
Skickas inom 5-8 vardagar
Häftad, Engelska, 1988
1 105 kr
Skickas inom 10-15 vardagar
The present volume and volume I "Hector: New Ways in Education and Research" present the results of HECTOR, the four year cooperation project between the Univer sity of Karlsruhe and IBM Germany (represented by the European Networking Center and Scientific Center in Heidelberg as well as IBM Research in Riischlikon). The pro ject was started in spring 1984 and will end in April 1988 with a congress. This congress addresses the scientific community to present experiences and results with a program of lectures and demonstrations. The HECTOR Project has two major aspects: the first is to explore new ways in uni versity education. The second aspect of HECTOR comprises basic research work to develop new technological concepts for the establishment of computer communication networks, supporting academic research and education in all disciplines. The underlying concept is that now and in the future, computer, software and commu nication systems which are required for the broad range of scientific and educational tasks will be of different technical orientation and made by different manufacturers. These diverse systems will, however, need to coexist and cooperate side by side. Today, in most cases, different hardware and software architectures of different manu facturers prevent a scientist or student from choosing freely the computer and software which offers the best alternative for solving his or her current problem. The mutual cooperation of the academic users is also hindered substantially by the many incompa tibilities present. The users' future is therefore transparency in a heterogeneous envi ronment.
Häftad, Tyska, 2012
555 kr
Skickas inom 10-15 vardagar
Häftad, Engelska, 2012
1 073 kr
Skickas inom 10-15 vardagar
Few fields of research in the earth sciences have produced as much data and litera ture as the study of carbonate sediments and rocks. The past 25 years in particular, have seen a significant increase in studies concerning modern marine and fresh water carbonates. With the present worldwide interest in oceanographic research, marine carbonates have received the bulk of the attention, particularly with respect to shallow-water sediments. However, in terms of the variety of environ ments, compositions and modes of formation, non-marine carbonates probably encompass a wider spectrum than do marine types. Our purpose is to present a two-volume treatise on carbonate sediments and rocks, both marine and non-marine. We have confined ourselves to the discussion of modern (Holocene) environments, sediments and components, assuming that the compilation of these data will not only be relevant to those working with modern carbonates but will also serve as a necessary reference source for those interested in ancient analogs. The first volume, by MILLIMAN, deals almost exclu sively with marine environments, while the second volume, by MULLER and FORST NER, will concentrate on the non-marine carbonates.
Häftad, Tyska, 2011
555 kr
Skickas inom 10-15 vardagar
Häftad, Tyska, 2012
505 kr
Skickas inom 10-15 vardagar
Der vorliegende Band ist Bestandteil einer Buchreihe, die auBerdem die bereits vor liegenden Bande »Grundlagen der Lebensmittelmikrobiologie«( und »Mikrobiologie tierischer Lebensmittel«( umfaBt. Die Gliederung des recht heterogenen Gebietes der Mikrobiologie pflanzlicher Lebens mittel erfolgte nach Lebensmittelgruppen. Dabei wurde auch die direkte Verwertung von MikroorganismenzelIen als Lebens- und Futtermittel sowie die Nutzung von Mikroorganismen zur Herstellung von alkoholischen Getranken, organischen Sauren, Polysacchariden, Fetten, Aminosauren, Proteinen, Enzymen und Vitaminen ein bezogen. Wir gehen dabei von der Voraussetzung aus, daJ3 diese Produkte im wesent lichen aus Rohstoffen pflanzlicher Herkunft gewonnen werden. Damit ergibt sich ein fIieBender Dbergang zu den Zweigen der technischen Mikrobiologie. Da abge sehen von seltenen Ausnahmen aIle pflanzlichen Lebensmittel bei der Be- und Ver arbeitung mit Trinkwasser in Beriihrung kommen, wurde diesem lebensnotwendigen Lebensmittel ein eigenes Kapitel gewidmet. Es war naheliegend, auch die Mikro biologie der pflanzlichen GenuBmittel Kaffee, Tee und Tabak sowie der Gewiirze mit einzubeziehen. AusfUhrliche Darstellungen tiber die Verfahrensgrundlagen zur Erhaltung von Lebensmitteln, die mikrobiellen Lebensmittelvergiftungen sowie die allgemeine Mikrobiologie sind in dem Grundlagenband zu finden. Das vorliegende Werk ist in erster Linie als Lehrbuch fUr die Ausbildung von Fach und Hochschulingenieuren ftir die Lebensmittelindustrie gedacht. Um den Umfang in bestimmten Grenzen zu halten, wurden mikrobiologische Methoden der Lebens mitteluntersuchung prinzipielI nicht aufgenommen. Dagegen wurden notwendiger weise technologische Grundlagen beriicksichtigt, denn die Mikrobiologie pflanzlicherLebensmittel kann nur in Verbindung mit der entsprechenden Technologie gesehen werden. Um die dynamische Entwicklung des Wissensgebietes zu verdeutlichen, wurden historische Aspekte im begrenzten MaBe einbezogen.
Häftad, Tyska, 2013
768 kr
Skickas inom 5-8 vardagar
Häftad, Tyska, 2024
190 kr
Skickas inom 3-6 vardagar